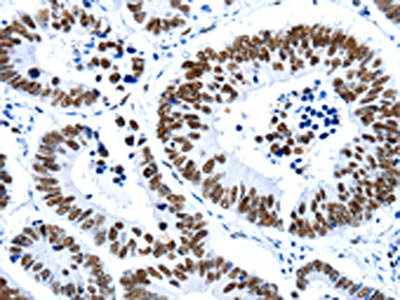

HDAC2 Antibody
-
中文名稱:HDAC2兔多克隆抗體
-
貨號:CSB-PA017043
-
規格:¥1100
-
圖片:
-
The image on the left is immunohistochemistry of paraffin-embedded Human breast cancer tissue using CSB-PA017043(HDAC2 Antibody) at dilution 1/17, on the right is treated with synthetic peptide. (Original magnification: ×200)
-
The image on the left is immunohistochemistry of paraffin-embedded Human colon cancer tissue using CSB-PA017043(HDAC2 Antibody) at dilution 1/17, on the right is treated with synthetic peptide. (Original magnification: ×200)
-
-
其他:
產品詳情
-
Uniprot No.:
-
基因名:
-
別名:D10Wsu179e antibody; HD 2 antibody; HD2 antibody; HDAC 2 antibody; Hdac2 antibody; HDAC2_HUMAN antibody; Histone deacetylase 2 (HD2) antibody; Histone deacetylase 2 antibody; OTTHUMP00000017046 antibody; OTTHUMP00000227077 antibody; OTTHUMP00000227078 antibody; RPD3 antibody; transcriptional regulator homolog RPD3 antibody; YAF1 antibody; YY1 associated factor 1 antibody; YY1 transcription factor binding protein antibody; Yy1bp antibody
-
宿主:Rabbit
-
反應種屬:Human,Mouse
-
免疫原:Synthetic peptide of Human HDAC2
-
免疫原種屬:Homo sapiens (Human)
-
標記方式:Non-conjugated
-
抗體亞型:IgG
-
純化方式:Antigen affinity purification
-
濃度:It differs from different batches. Please contact us to confirm it.
-
保存緩沖液:-20°C, pH7.4 PBS, 0.05% NaN3, 40% Glycerol
-
產品提供形式:Liquid
-
應用范圍:ELISA,IHC
-
推薦稀釋比:
Application Recommended Dilution ELISA 1:1000-1:2000 IHC 1:15-1:50 -
Protocols:
-
儲存條件:Upon receipt, store at -20°C or -80°C. Avoid repeated freeze.
-
貨期:Basically, we can dispatch the products out in 1-3 working days after receiving your orders. Delivery time maybe differs from different purchasing way or location, please kindly consult your local distributors for specific delivery time.
-
用途:For Research Use Only. Not for use in diagnostic or therapeutic procedures.
相關產品
靶點詳情
-
功能:Responsible for the deacetylation of lysine residues on the N-terminal part of the core histones (H2A, H2B, H3 and H4). Histone deacetylation gives a tag for epigenetic repression and plays an important role in transcriptional regulation, cell cycle progression and developmental events. Histone deacetylases act via the formation of large multiprotein complexes. Forms transcriptional repressor complexes by associating with MAD, SIN3, YY1 and N-COR. Interacts in the late S-phase of DNA-replication with DNMT1 in the other transcriptional repressor complex composed of DNMT1, DMAP1, PCNA, CAF1. Deacetylates TSHZ3 and regulates its transcriptional repressor activity. Component of a RCOR/GFI/KDM1A/HDAC complex that suppresses, via histone deacetylase (HDAC) recruitment, a number of genes implicated in multilineage blood cell development. May be involved in the transcriptional repression of circadian target genes, such as PER1, mediated by CRY1 through histone deacetylation. Involved in MTA1-mediated transcriptional corepression of TFF1 and CDKN1A.
-
基因功能參考文獻:
- Results found that HDAC2 expression is up-regulated in patients with chronic diabetic foot ulcer and in high glucose induced endothelial progenitor cells. PMID: 30063937
- Comparative molecular docking studies of the lead RH01652 with class I HDACs (HDAC1, HDAC2, HDAC3, and HDAC8) shows higher binding affinity towards HDAC2. Thus, lead RH01652 could serve as template to design novel and potent inhibitor of HDAC2. PMID: 29932788
- human immortalized telencephalic/mesencephalic microglial cells reveal significant upregulation of HDAC2 in the presence of the potent microglial activator lipopolysaccharide PMID: 29803514
- we found that HDAC2 was the direct target of miR-31 by binding to 3'-UTR from the results of luciferase reporter assays, qRT-PCR, and western blotting. HDAC2 played an activation role in tumor growth, whose expression is upregulated and inversely associated with miR-31 levels PMID: 29333444
- data indicate that the obesity impacts on H4ac levels and that strenuous exercise leads to an enhanced chronic low-grade inflammation profile in obesity via an imbalance on H4ac/HDAC2. PMID: 29142617
- Knockdown of HDAC2 completely mimicked the effects of 1,25(OH)2D3 on PTEN gene expression. PMID: 28737824
- Muscle biopsies of chronic obstructive pulmonary disease significantly correlated with HDAC2 decrease compared to controls. PMID: 28526090
- With tissue microarrays of hepatocellular carcinoma (HCC) patients, we determined the prognostic values of the core genes in the network and found that RAD21, CDK1, and HDAC2 expression levels were negatively associated with overall survival for HCC patients. PMID: 28434945
- Combined treatment with the histone deacetylase inhibitors (HDACi) suberoylanilide hydroxamic acid plus 5-fluorouracil (5-FU) and oxaliplatin (Oxa) reduced the level of HDAC2 expression in HT-29 cells. PMID: 27283986
- miR-223 controls the expression of CX3CL1 by targeting HDAC2 in chronic obstructive pulmonary disease patients and mouse models of the disease. PMID: 26864305
- Data show that BRCA2 was required for HDAC2/3 association with acetylated BubR1 in nocodazole (Noc)-arrested cells. PMID: 28985013
- study defines two classes of HDAC2 targets in human cells, with a dependence of HDAC1 on HDAC2 at one class of targets, and distinguishes unique functions for HDAC2 PMID: 28982113
- This study demonstrated that the Expression of HDAC2 Transcript Is Reduced in Dorsolateral Prefrontal Cortex of Patients with Schizophrenia. PMID: 27959513
- The findings suggest that miR-455-3p plays a critical role during chondrogenesis by directly targeting HDAC2/8 and promoting histone H3 acetylation. PMID: 27638301
- report the interaction between CFTR and HDAC2, and its involvement in the development of Ph+ leukemia PMID: 28235656
- USP4 inhibits p53 and NF-kappaB through deubiquitinating and stabilizing HDAC2 PMID: 26411366
- HDAC2 controls ciliogenesis independently of Kras, which facilitates Aurora A expression. These studies suggest that HDAC2 is a novel regulator of primary cilium formation in PDAC cells. PMID: 28028031
- the current findings implicate the HDAC2/miR-101/AMPK pathway as a critical mediator of AD pathogenesis. These studies also highlight the importance of epigenetics in AD and provide novel therapeutic targets. PMID: 28202389
- HDAC2 upregulation is associated with hepatocellular carcinoma. PMID: 27342975
- Suggest that HDAC2 can trigger migration and invasion of non-small cell lung carcinoma cells by activating NF-kappaB to up-regulate fibronectin expression. PMID: 27665474
- KLF4 acts as a tumor suppressor or oncogene to activate or repress target gene transcription depending on its acetylation status, which is regulated by p21 and CK2 interaction-mediated HDAC2 phosphorylation PMID: 26729194
- Decreased HDAC2 expression is associated with cisplatin resistance in ovarian cancer. PMID: 26683361
- In cigarette smoke extract-exposed airway epithelial cells and macrophages, HDAC2 is excessively ubiquitinated and degraded in the proteasome attributed to low expression of USP17. PMID: 26617781
- The results imply that HDAC2 is involved in the transcriptional regulation of human odontoblasts in vivo. PMID: 22297573
- Endothelial-Mesenchymal Transition is initiated by recruitment of aberrantly phosphorylated DNMT1 to the RASAL1 CpG island promoter by HDAC2, causing aberrant promoter methylation and transcriptional suppression. PMID: 26815200
- Selective inhibition of HDAC2 in lung tumor cell causes survivin downregulation through activation of p53, which is mediated by downregulation of Mdm2. PMID: 25605253
- our study revealed that HDAC2 is overexpressed in colorectal cancer (CRC) cells; its knockdown can increase the sensitivity of CRC cells to doxorubicin via upregulation of ABCB1 PMID: 26846508
- Pancreatic adenocarcinoma patients with enhanced HDAC-1 and -6 expression showed significantly longer survival times compared to those with low expression, while a borderline association concerning HDAC-2 expression was noted. PMID: 26502922
- Lymphocyte senescence in COPD is associated with loss of HDAC2 in CD28nullCD8+ T and NKT-like cells. PMID: 26498345
- HDAC2 may not confer susceptibility to Schizophrenia in Han Chinese. PMID: 26063464
- In endothelial dysfunction, HDAC2 levels were reciprocally regulated by ectopic expression of NEDD8 and the de-NEDDylating enzyme SENP8. PMID: 25655932
- Aberrant overexpression of HDACs in basal cells of IPF lungs may contribute to the bronchiolisation process in this disease. Similarly, generation and apoptosis resistance of IPF fibroblasts are mediated by enhanced activity of HDAC enzymes. PMID: 26359372
- HDAC2 sumoylation is important for NF-kappaB-dependent gene expression and for the resistance of cell against stress PMID: 25704882
- HDAC2 inhibition reduces proliferation and induces apoptosis via the caspase-dependent pathway in human glioma cell lines, possibly by activating the p53 signaling pathway. PMID: 25523932
- Data indicate that that hstone deacetylase 2 (HDAC2) has a specific role in leukemogenesis. PMID: 25473896
- HDAC3 is an essential target to disrupt HIV-1 latency, and inhibition of HDAC2 may also contribute to the effort to purge and eradicate latent HIV-1 infection. PMID: 25136952
- BRG1/HDAC2 and beta-catenin constitute a manipulative apparatus at the transcription start site to play opposite but complementary roles in regulating hTERT expression. PMID: 25486475
- HDAC2 plays a central role in coupling lysine acetylation to synaptic plasticity and mediates many of the effects of HDAC inhibition in cognition and disease. PMID: 25492968
- Data suggest that p15RS (p15INK4b-related sequence) acts as an intrinsic transcriptional repressor for Wnt/beta-catenin-mediated gene transcription through recruiting HDAC2 histone deacetylase. PMID: 25697359
- Simultaneous loss of Hdac1 and Hdac2 resulted in loss of hematopoietic stem cells. PMID: 24763403
- our data suggested that cPA may have beneficial effects in inflammation-related cardiovascular disease by controlling HDAC2 regulation PMID: 25013374
- HDAC2 silencing in HCC cells also strongly inhibited PPARgamma signaling. PMID: 24958469
- inhibitory of cell growth by melittin might be led by HDAC2-mediated PTEN upregulation, Akt inactivation, and inhibition of the PI3K/Akt signaling pathways PMID: 24788349
- Osteocalcin levels were decreased, an effect induced at the transcriptional level, and were strongly correlated with inhibition of HDAC2. PMID: 24105979
- these results indicated that the potential of specific inhibition of HDAC2 by small molecular chemicals may lead to future therapeutic agents in human renal cancer treatment. PMID: 24390319
- The proliferation inhibition and cell cycle arrest mediated by downregulated HDAC2 expression may be tightly associated with the decrease of cyclin D1, cyclin E, and cdk2 proteins expression. PMID: 24965412
- PELP1 regulates tumor metastasis by controlling the expression and functions of the tumor metastasis suppressors miR-200a and miR-141 PMID: 23975430
- HDAC2 is a critical regulator of Arg2 expression and thereby endothelial nitric oxide and endothelial function. PMID: 24833798
- Data indicate prominent changes in urothelial cancer cell lines (UCC) were HDAC2 and/or HDAC8 up-regulation. PMID: 22944197
- our study has found no association between HDAC2/HDAC3 gene polymorphisms and schizophrenia in the Chinese Han population PMID: 23857786
顯示更多
收起更多
-
亞細胞定位:Nucleus. Cytoplasm.
-
蛋白家族:Histone deacetylase family, HD type 1 subfamily
-
組織特異性:Widely expressed; lower levels in brain and lung.
-
數據庫鏈接:
Most popular with customers
-
YWHAB Recombinant Monoclonal Antibody
Applications: ELISA, WB, IHC, IF, FC
Species Reactivity: Human, Mouse, Rat
-
Phospho-YAP1 (S127) Recombinant Monoclonal Antibody
Applications: ELISA, WB, IHC
Species Reactivity: Human
-
-
-
-
-
-